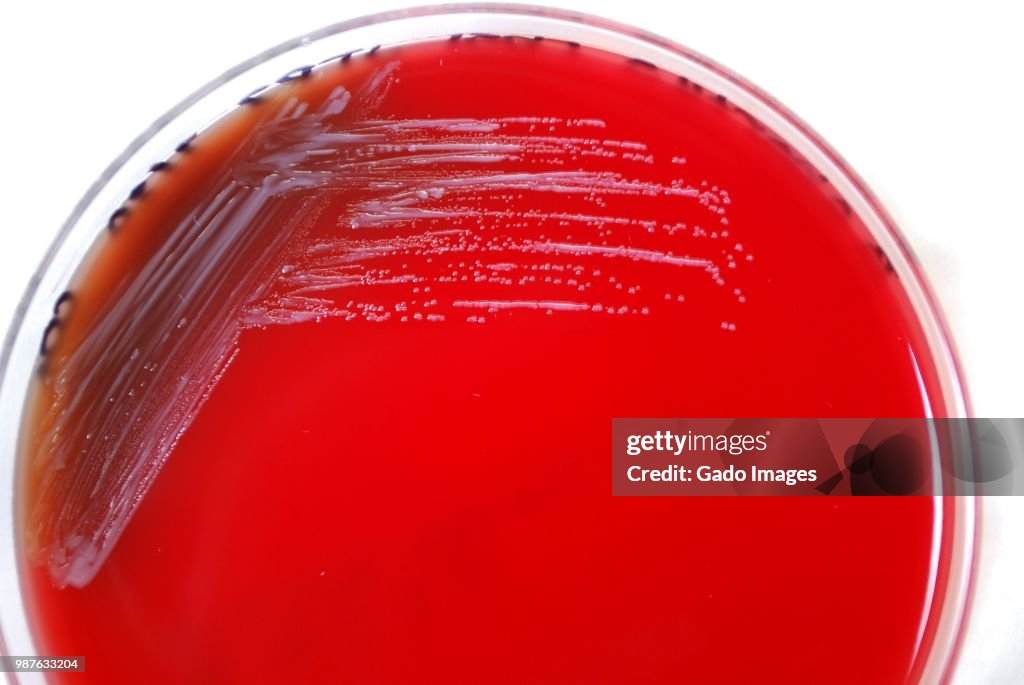
Brucella Abortus Bacteria

Brucella Abortus Bacteria - stock photo
Colonial morphology of Gram-negative Brucella abortus bacteria grown 48 hours on a medium of sheep's blood agar (SBA), 2010. Image courtesy Centers for Disease Control (CDC) / Dr Todd Parker, Audra Marsh. (Photo by Smith Collection/Gado/Getty Images)

Get this image in a variety of framing options at Photos.com.
PURCHASE A LICENSE
All Royalty-Free licenses include global use rights, comprehensive protection, simple pricing with volume discounts available
€300.00
EUR
Getty ImagesBrucella Abortus Bacteria High-Res Stock Photo Download premium, authentic Brucella Abortus Bacteria stock photos from 51łÔąĎÍř Explore similar high-resolution stock photos in our expansive visual catalogue.Product #:987633204
Download premium, authentic Brucella Abortus Bacteria stock photos from 51łÔąĎÍř Explore similar high-resolution stock photos in our expansive visual catalogue.Product #:987633204
Download premium, authentic Brucella Abortus Bacteria stock photos from 51łÔąĎÍř Explore similar high-resolution stock photos in our expansive visual catalogue.Product #:987633204
Download premium, authentic Brucella Abortus Bacteria stock photos from 51łÔąĎÍř Explore similar high-resolution stock photos in our expansive visual catalogue.Product #:987633204€300€40
Getty Images
In stockDETAILS
Credit:
51łÔąĎÍř #:
987633204
License type:
Collection:
Photodisc
Max file size:
5300 x 3547 px (17.67 x 11.82 in) - 300 dpi - 3 MB
Upload date:
Location:
United States
Release info:
No release required
Categories:
- Bacterium Photos
- Blood Photos
- Blood Agar Photos
- Brucella Abortus Photos
- Color Image Photos
- Healthcare And Medicine Photos
- Horizontal Photos
- Immunology Photos
- Laboratory Photos
- Medical Research Photos
- Medical Test Photos
- No People Photos
- Petri Dish Photos
- Photography Photos
- Research Photos
- Science Photos
- Scientific Experiment Photos
- Sheep Photos
- USA Photos